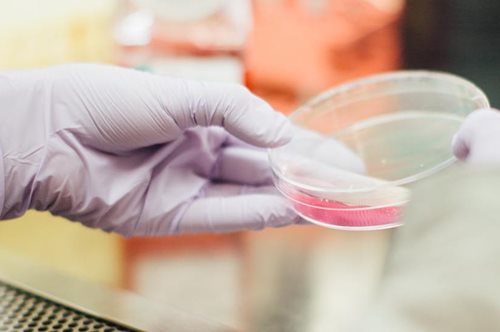
Κόλλησες τον ιό HPV;  Μάθε γιατί δεν αρκεί το τεστ ΠΑΠ

Κόλλησες τον ιό HPV; Μάθε γιατί δεν αρκεί το τεστ ΠΑΠ
Ο ειδικός απαντάει σε όλες τις ερωτήσεις σου.
Κάθε γυναίκα αξίζει τον καλύτερο προληπτικό έλεγχο
Ο συνδυασμός ThinPrep Pap Test και Aptima HPV test, γνωστός ως Co-testing, προσφέρει την καλύτερη δυνατή προστασία.
Δωρεάν προληπτικές γυναικολογικές εξετάσεις στις 6 Μαρτίου από το δήμο Αθηναίων
Ενημερωτική καμπάνια αλλά και δωρεάν προληπτικές γυναικολογικές εξετάσεις περιλαμβάνουν οι δράσεις του Αρεταίειου νοσοκομείου σε συνεργασία με τον Δήμο Αθηναίων.
Γιατί ο Γεώργιος Παπανικολάου δεν πήρε το βραβείο Νόμπελ ενώ ανακάλυψε το τεστ ΠΑΠ
Και τις δύο φορές η Bασιλική Aκαδημία της Στοκχόλμης αρνήθηκε την κορυφαία επιβράβευση στον άνθρωπο που έφερε την επανάσταση στη διάγνωση για τον καρκίνο.